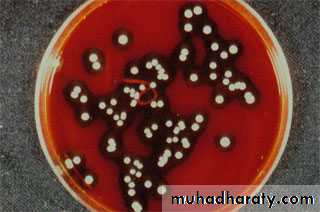
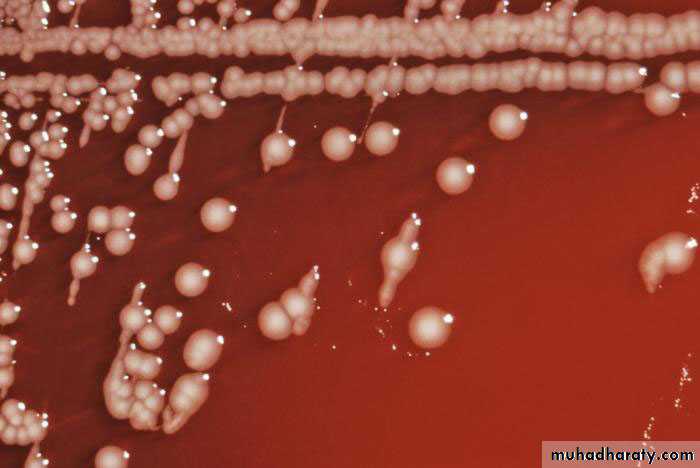
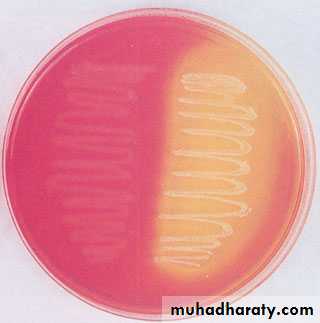
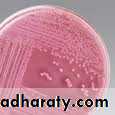
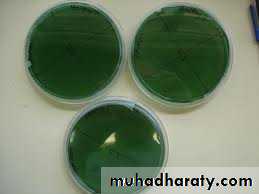
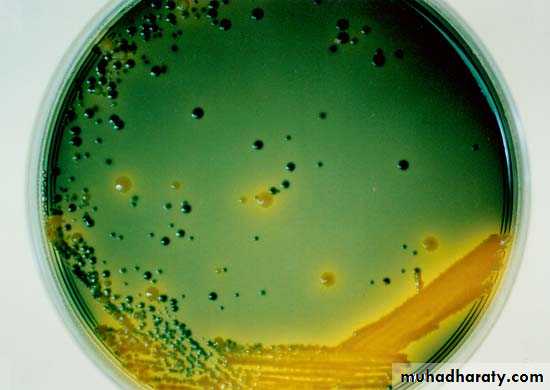
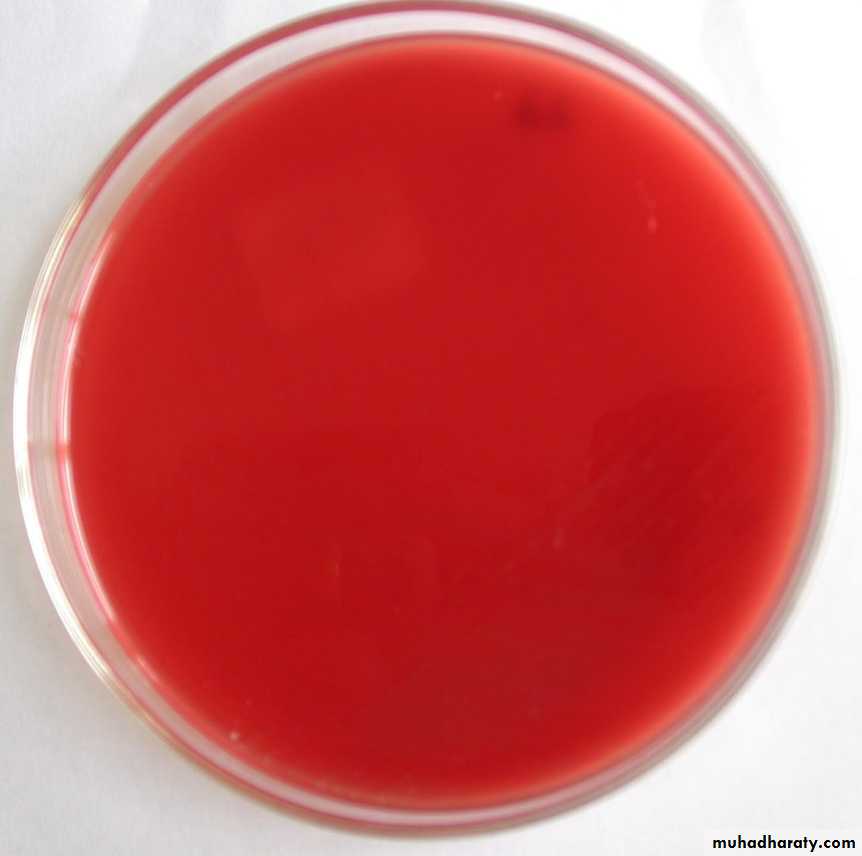

20/10/2015
1Culture Media Preparation
Practical Medical Microbiology
Culture Media Preparation
Culture Media Preparation
2Bacteria have to be grown (cultured) for them to be identified.
By appropriate procedures they have to be grown separately (isolated) on culture media and obtained as pure for study.
Broth Media :Liquid medium – diffuse growth
Solid medium (Agar Media)
discrete colonies.• 20/10/2015
TYPES OF CULTURE MEDIABASED ON THE AGAR CONCENTRATION (Consistency):1. Solid media – 2% agar.2. Liquid media – broth media absence of agar.3. Semi solid media – 0.2-0.5% agar
BASIC NUTRITIONAL REQUIREMENTS
WATER.CARBON SOURCE.
NITROGEN SOURCE.
INORGANIC SALTS.Phosphates. Sulfates.Sodium. Potassium.Magnesium. Iron.Manganese. Calcium.
BACTERIAL VITAMINS.Thiamine riboflavinnicotinic acid pyridoxinefolic acid vitamine B12.
GASEOUS REQUIREMENTS
OXYGEN Obligate aerobesFacultative anaerobes.Microaerophillic.Obligate anaerobes.CARBONDIOXIDE:Capnophillic.
TEMPERATURE
Psychrophillic – bacteria that grows at lower temeperature – below 20ºC.Mesophillic – bacteria that grows at 25ºC-40ºC. optimum temp range - 37ºC.
Thermophillic – bacteria that grows at high temperatures - 55ºC-80ºC.
CULTURE MEDIABASIC INGREDIENTS
PROTEIN SOURCE – peptone (a complex mixture of partially digested proteins).- special brands – Neopeptone & proteose peptone- digest broths can also be used.- meat extract (Lab Lemco).
MINERAL SALT – sodium chloride.
WATER- source of hydrogen and oxygen.
Culture Media Preparation8
Agar
Used for preparing solid medium
Obtained from seaweeds.
No nutritive value
Not affected by the growth of the bacteria.
Melts at 98oC & sets at 42oC
2% agar is employed in solid medium
Culture Media Preparation
9• Based on their consistency
• a) solid medium
• b) liquid medium
• c) semi solid medium
• Based on the constituents/ ingredients
• a) simple medium
• b) complex medium
• c) synthetic or defined medium
• d) Special media
Types of culture media
Culture Media Preparation
10
Special media
Enriched media
• Enriched with Blood,serum,extrapeptones,egg& vitamins
• Used for: cultivation of all fastidious organisms,
• (haemophilus influenza&Streptococcus spp.)
• Examples: Blood agar &chocolate agar
Enrichment media
Contains substances that stimulates the desired bacteria or has inhibitory substances that inhibits the growth of unwanted bacteria.
Or otherwise promotes the growth of a particular organism and prevent the growth of normal competitors.
Differential media”:
are specialized media that allow identification of organisms based on their growth
and appearance on the media
Selective media
are specialized media that allows the growth of one type or certain types of bacteria ,fungi , while inhibiting the growth of other organism
Enriched media
Such as blood agar
Culture Media Preparation
12which is differential for mannitol
fermentationLike Staphylococcus aureus change
the color of agar from pink to yellow
Differential media
Mannitol salt agar
MacConkey agar
which is differential for lactose fermentation Ex: E.coliFrom non lactose fermenters
Ex: salmonella,shigella
MacConkey agar
Differential media
Selective media
Thiosulphate citrate bile salt sucrose (TCBS) which is selective for Vibrio cholerae
MacConkey agar which is selective for EnterobacteriaceaeTCBS agar
Culture MediaChemically defined media: Exact chemical composition is known
Complex media: Extracts and digests of yeasts, meat, or plants
Nutrient broth
Nutrient agar
SYNTHETIC & SEMISYNTHETIC MEDIUM
SYNTHETIC OR DEFINED MEDIUM:Prepared from pure chemical substances and the exact composition of the medium is known.Used for various special studies such as metabolic requirements.EXAMPLE: Dubo’s mediumSEMISYNTHETIC OR SEMIDEFINED MEDIUM:Composition is approximately known.
COMPLEX MEDIUM
Exact chemical composition of ingredients of culture medium is not known.
Widely used for the cultivation of bacteria for diagnostic purposes.
11/28/2010
Culture Media Preparation19
Solid media – contains 2% agar
Colony morphology, pigmentation, hemolysis can be appreciated.
Eg: Nutrient agar, Blood agar
Liquid media(Broth media) – no agar.
For inoculum preparation, Blood culture, for the isolation of pathogens from a mixture.
Eg: Nutrient broth
Semi solid medium – 0.5% agar.
Eg: Motility mediumCulture Media Preparation
20Blood agar
Chocolate agarUrease medium
22
Culture Media Preparation
STEP 1:
Correct amount of Dehydrated medium is weighed on balance.
Culture Media Preparation
23Dehydrated medium is dissolved in
a measured amount of
distilled water.
STEP 2:
Culture Media Preparation
24Tubes and conical of media are sterilized in an autoclave for 15 to 20 minutes at 15 psi steam pressure or (1 bar).
STEP 3:
25Culture Media Preparation
STEP 4: